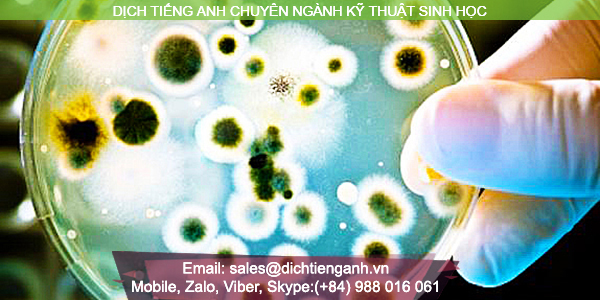

DỊCH THUẬT TIẾNG ANH CHUYÊN NGÀNH KỸ THUẬT SINH HỌC
Kể từ lần đầu tiên được đưa vào nghiên cứu và giảng dạy tại Đại học Bang Mississippi (Mỹ) khoảng năm 1967, kỹ thuật sinh học đã trở thành ngành khoa học mang tính thực tiễn cao, liên quan mật thiết đến sự tồn tại của loài người. Từ hóa học, dược học đến y học hoặc môi trường, ngành “kỹ thuật sinh học” đều lấn sân tới và chịu tác động trực tiếp. Những công trình nghiên cứu về tế bào, hệ miễn dịch, hóa protein hay sinh vật vĩ mô, vi mô….với mục đích chữa bệnh, phòng bệnh, bảo vệ môi trường, sản xuất hay kéo dài tuổi thọ đều có sự góp sức của kỹ thuật sinh học. Bộ môn này trong ngành sinh học rộng lớn còn mang tính nhân đạo sâu sắc khi đã cùng với một số ngành khoa học liên đới khác làm nên kiệt tác “công nghệ thụ tinh nhân tạo”, mang đến niềm hạnh phúc lớn lao cho những bà mẹ hiếm muộn. Ở nước ta hiện nay, duy nhất có trường ĐH Bách Khoa Hà Nội đưa ngành kỹ thuật sinh học vào đào tạo chính quy cũng như hợp tác quốc tế để phát triển rộng rãi ngành khoa học này vào sự nghiệp công nghiệp hóa hiện đại hóa đất nước.
Được coi là một nhánh của ngành khoa học sinh học rộng lớn, kỹ thuật sinh học đã áp dụng sự tiến bộ của khoa học và công thức chính xác của toán học để nghiên cứu và thực nghiệm. Hơn nữa kỹ thuật sinh học không đứng một mình, nó luôn gắn liền với những ngành nghề khác như y học, thực phẩm, máy móc và dược phẩm…Do đó dịch tài liệu tiếng anh kỹ thuật sinh học đòi hỏi một khối lượng kiến thức tổng hợp liên ngành và vốn từ vựng tiếng anh chuyên nghành chuẩn xác. Kỹ thuật sinh học được khởi nguồn nghiên cứu từ Phương Tây, tài liệu và nhiều công trình khoa học tiên tiến đều bắt nguồn từ các nước công nghiệp phát triển. Hơn nữa, vì là bộ môn khoa học do đó có nhiều xu hướng, quan điểm, công trình nghiên cứu trái chiều nhau ở mỗi cá nhân, tổ chức hay quốc gia nào đó. Đó cũng là một trong những khó khăn cho công tác dịch tài liệu tiếng anh về kỹ thuật sinh học hiện nay.
Với tiêu chí biến khó khăn thành lợi thế, Ulytan đã chú trọng nâng cao đội ngũ nhân lực và công cụ hỗ trợ dịch thuật tiếng anh để khắc phục những hạn chế trong công tác dịch tài liệu tiếng anh về kỹ thuật sinh học. Bằng cách luôn theo sát những thông tin, tư liệu kỹ thuật sinh học từ những đơn vị, tổ chức, công ty cũng như trường đại học danh tiếng như TT ứng dụng Kỹ thuật sinh học, Đại học Rice, Tạp chí kỹ thuật sinh học, Viện Công nghệ sinh học,…Ulytan đã tạo riêng cho mình một bộ từ điển bao gồm từ vựng tiếng anh chuyên ngành và kiến thức chuyên môn. Điều đó đáp ứng được nhu cầu cũng như chất lượng dịch tài liệu tiếng anh về kỹ thuật sinh học đảm bảo chất lượng mà chỉ nhờ vào dịch tiếng anh trên máy, dịch tiếng anh google hoặc dịch dựa vào từ điển tiếng anh thông thường sẽ không thể có được.
Với vị thế là công ty dịch thuật tiếng anh chuyên ngành số một Việt Nam thành lập từ ngày 22.08.2008 chiếm 80% thị phần, Ulytan luôn đi đầu trong việc đầu tư vào các yếu tố tạo nên sự thành công như:
- Yếu tố Công nghệ:
+ Mạng máy tính hiện đại đảm chạy tốt các ứng dụng.
+ Phần mềm diệt Virus kaspersky.
+ Mạng Internet cáp quang phát wifi đảm bảo mọi máy tính di chuyển tiện lợi trong cả 04 của tòa nhà mà công ty đang hoạt động.
+ Server riêng, đảm bảo upload và download dữ liệu với dung lượng lớn, đảm bảo không xảy ra tắc nghẽn mạng giúp cho việc trao đổi tài liệu giữa công ty với khách hàng, giữa công ty với cộng tác viên diễn ra nhanh chóng, thuận lợi mà không phụ thuộc vào các dịch vụ của bên thứ ba.
+ Ứng dụng các phần mềm dịch thuật nổi tiếng Trados, phần mềm convert (ABBYY FineReader ) tài liệu từ File PDF hoặc file ảnh sang dạng Word, các phần mềm để phục vụ công việc dịch thuật khác như Photoshop, Corel, Autocad, Frame maker v…v. Trong đó phần mềm Trados và ABBYY FineReader, Kaspersky đã được Ulytan đầu tư mua bản quyền.
-Yếu tố con người: Đội ngũ quản lý và nhân viên chuyên nghiệp cùng đông đảo đội ngũ chuyên gia tiếng anh giàu kinh nghiệm về lĩnh vực chuyên môn.
Tất cả những điều trên chứng minh rằng, giải pháp tối ưu cho bạn là sự giúp đỡ từ những chuyên gia tiếng anh am hiểu về kỹ thuật sinh học. Việc thuê dịch trong thời đại công nghệ thông tin hiện nay mang lại vô số những lợi ích. Thay vì ngồi hàng giờ, hàng tuần, thậm chí cả tháng để tra một thuật ngữ tiếng anh về lĩnh vực kỹ thuật sinh học. Bạn hãy để các chuyên gia của chúng tôi giúp bạn hoàn thành trong khoảng thời gian nhanh gấp nhiều lần so với việc bạn tự dịch. Nói tóm lại thời gian, tiền bạc, công sức là chi phí cơ hội bạn tiết kiệm được khi đến với chúng tôi. Ulytan cam kết sẽ giúp bạn tiếp cận các tài liệu về kỹ thuật sinh học một cách sớm nhất thông qua các bản dịch tiếng anh chuyên ngành kỹ thuật sinh học.
Đôi lời của Ms Ann.Giám sát chất lượng tiếng Anh tại Ulytan
Cho dù bạn có là một chuyên gia về ngôn ngữ thì chuyện dịch nhầm đôi đũa với que tre vẫn có thể xảy ra. Nhưng nếu bản dịch của các bạn được kiểm tra lại bởi chính người bản địa thì chắc chắn việc dịch sai thuật ngữ hoặc văn phong sẽ rất khó diễn ra.
DỊCH GIẢ LÀ CÁC GIẢNG VIÊN ĐẠI HỌC VÀ NGƯỜI BẢN ĐỊA GIÀU KINH NGHIỆM
Được Tham gia dịch thuật cùng đội ngũ tài năng của Ulytan trong các dự án lớn về tiếng nhật như giáo trình Y tá điều dưỡng của trường đại học kỹ thuật y Hải Dương, tôi thực sự rất vui vì đã góp được một phần nhỏ vào sự phát triển chung của công ty dịch thuật với bề dày kinh nghiệm 09 năm này.
BÀ LƯƠNG THÙY DƯƠNG: THẠC SỸ, GIẢNG VIÊN TIẾNG NHẬT ĐẠI HỌC BÁCH KHOA HÀ NỘI
Khi tham gia các dự án dịch thuật của Ulytan, tôi thường được tiếp xúc với các chuyên ngành đa dạng, giúp tôi có thêm kiến thức phong phú để truyền đại lại cho các bạn sinh viên. Tôi thực sự rất hứng thú khi được làm công việc phù hợp với chuyên môn và hỗ trợ cho chuyên môn của mình như thế này.



